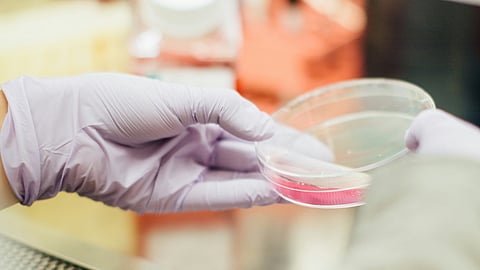

The researchers at the Indian Institute of Science (IISc) and Jawaharlal Nehru Centre for Advanced Scientific Research (JNCASR) in Karnataka have developed a new paper-based platform that could help to quickly detect the presence of antibiotic resistance and disease-causing bacteria.
According to the WHO (World Health Organization), bacteria including E. coli and Staphylococcus aureus, have caused over a million deaths, and these numbers are to rise in the coming years.
The researchers enunciate that timely diagnosis can improve the efficiency of treatment.
Uday Maitra, a professor in the Department of Organic Chemistry at the Indian Institute of Science (IISc) in Bengaluru said that generally the doctor diagnoses the patient and gives them medicines. The patient then takes it for 2-3 days before realizing that the medicine is not working and goes back to the doctor. He also said that diagnosing that the bacteria is antibiotic-resistant from blood or urine tests takes time. So they wanted to reduce the time to diagnosis.
In a recent research paper published in the ACS Sensors, Professor Uday Maitra and his collaborators raised this challenge by developing a rapid diagnosis protocol that uses a luminescent paper-based platform to find the existence of antibiotic-resistant bacteria.
There are various ways a bacteria can develop resistance against antibiotics. Some bacteria can evolve and recognize medicine and eject it out from their cell and some other bacteria can produce beta-lactamase enzyme, which can hydrolysis or break down the beta-lactam ring (a key structural component of common antibiotics like penicillin and carbapenem) and render the medication ineffective.
The researchers at the IISc and JNCASR incorporated biphenyl-4-carboxylic acid within a supramolecular hydrogel matrix containing terbium cholate (TbCh). This hydrogel usually emits green fluorescence when UV light shines on it.
Arnab Dutta, a PhD student at IISc and lead author of the research paper said that in the lab they synthesized an enzyme substrate by tethering BCA to the cyclic (beta-lactam) ring that is a component of the antibiotic. When you mix this with TbCh hydrogel, there is no green emission as the sensitizer is concealed. He also said that in the presence of beta-lactamase enzyme, the gel will produce green emission. The beta-lactamase enzyme in the bacteria is the one that cuts open the drug and destroys and unmasks the sensitizer BCA. So the existence of beta-lactamase is signalled by green emission.
The team collaborated with a Tamil Nadu-based company, Adiuvo Diagnostics to design a customized, portable, and miniature imaging device called Illuminate Fluorescence Reader.
The researchers said that the instrument infuses hydrogel in a sheet of paper and reduces the cost significantly, it also comes up with different LEDs that shine UV radiation as required. They also said that the built-in camera captures green fluorescence from the enzyme and a software app measures the intensity which can aid in quantifying the bacterial load. They also said that the presence of antibiotic-resistant bacteria is signaled by luminescence and for nonresistant bacteria the green intensity was extremely low, making it easier to differentiate.
The IISc researchers along with Jayanta Haldar’s research group from JNCASR, studied their procedure on urine samples.
Professor Maitra said they used samples from healthy volunteers and added pathogenic bacteria to mimic urinary tract infections. It successfully produced the results within two hours.
To test this technology with the samples from the patients, now the researchers plan to link up with hospitals.
(Input from various sources)
(Rehash/Lavanya Beeraboina/MSM)